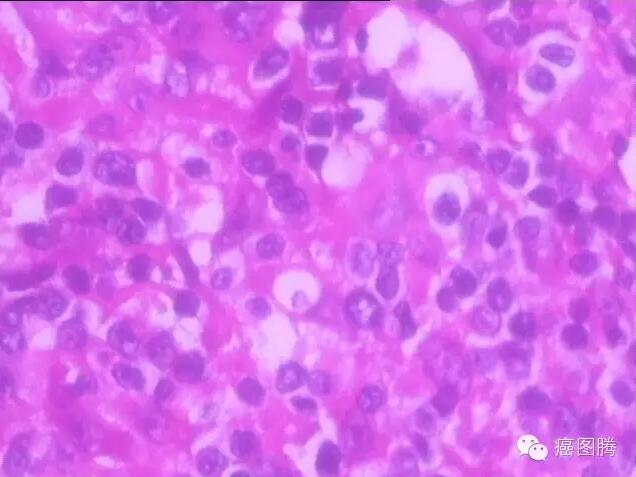
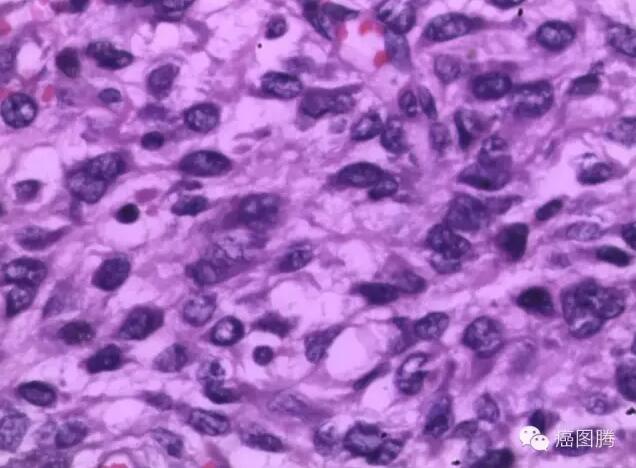
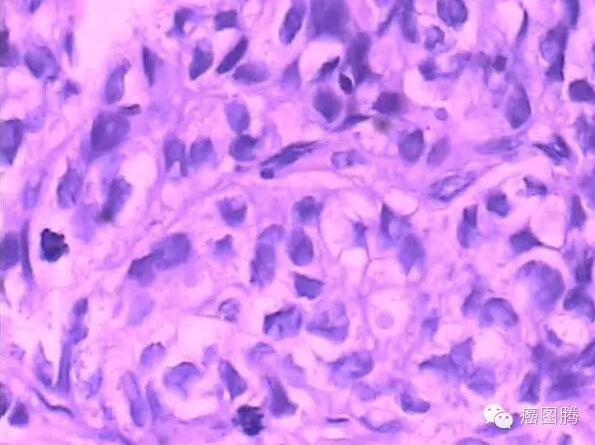

从一个正常细胞变为癌细胞要经过一个漫长的多阶段过程,通常从癌前病变发展为恶性肿瘤。
癌变是个体因素与外部因子之间相互作用的结果,深入理解癌变不同阶段的特点,及早发现癌前病变,可大大增加治疗机会,降低癌症的死亡率和经济负担。
炎症(inflammation)
炎症就是平时人们所说的“发炎”,是机体对于刺激的一种防御反应,表现为红、肿、热、痛和功能障碍。炎症是具有血管系统的活体组织对损伤因子所发生的防御反应。细菌、病毒和寄生虫等为炎症最常见的原因,放射性物质及紫外线等和机械损伤,外源性化学物质,以及各种途径进入人体的异物均可引起炎症。血管反应是炎症过程的中心环节,炎症的基本病理变化通常概括为局部组织的变质、渗出和增生。实质细胞常出现的变质包括细胞水肿、脂肪变性、凝固性或液化性坏死等;局部组织血管内的液体、蛋白质和血细胞通过血管壁渗出进入间质、休腔、体表或粘膜表面;致炎因子、组织崩解产物或某些理化因子刺激下,炎症局部的巨噬细胞、内皮细胞和纤维母细胞可增生。
慢性炎症
增生( hyperplasiai)
也可称为再生或新生(neogenesis),是指为修复缺损而发生的同种细胞的增生。炎症、再生、代偿等可引起组织细胞新生,本质上是为了修复缺损,而不是为了吸收坏死物质或消除致炎因子,再生的细胞与缺损的实质细胞完全相同。淋巴细胞新生对淋巴细胞白血病发生,血管新生对恶性实体肿瘤的生长、转移乃至预后都有着极其重要的意义。新生可发生于皮肤或粘膜表面的鳞状上皮,也可发生于腺上皮。上皮细胞异乎常态的增生,表现为增生的细胞大小不一,形态多样,核大而浓染,核浆比例增大,核分裂可增多但多呈正常核分裂像。细胞排列较乱,细胞层次增多,极向消失,但一般不见病理性核分裂;细胞增生从良性改变到恶性改变的中间站,是由量变到质变的关键点,因此,将非典型增生称之为“癌前病变”。

子宫内膜增生
赘生(neoplasia)
指机体局部组织细胞增生可形成的呈占位性块状突起,也称赘生物(neoplasm)。通常把生长在人体粘膜表面上正常结构的赘生物称为息肉,是粘膜面突出的一种赘生物,包括增生性、炎症性、错构瘤、腺瘤及其他肿瘤等。息肉临床表现多见腺瘤性息肉和某些胃肠道息肉综合征,这些病变虽属良性,但其中一部分有恶变倾向。胆固醇沉着于胆囊黏膜固有膜的巨噬细胞内使黏膜上皮增生、罗-阿窦增多及肌层增厚可形成息肉。胆固醇息肉、为炎症刺激可肉芽肿、非炎症腺瘤样增生,黏膜上皮局部变化、肌纤维增生与局限性腺肌瘤;腺瘤多为单发的有蒂息肉,外形可呈乳头状或非乳头状。

宫颈赘生物
化生(metaplasia)
化生也称为“癌前病变”,是指一种已分化组织转变为另一种分化组织的过程,并非由已分化的细胞直接转变为另一种细胞,而是由具有分裂能力的未分化细胞向另一方向分化而成,一般只能转变为性质相似的细胞。机体的一种组织由于细胞生活环境改变或理化因素刺激,在形态和机能上变为另一种组织的过程,是机体的一种适应现象。如支气管黏膜的柱状上皮组织长期受刺激变为鳞状上皮组织。常见的化生有上皮化生、骨与软骨化生、浆膜化生、脂肪化生和骨髓化生。化生是局部组织在病理情况下的一种适应性表现,在一定程度上对人体可能是有益的。鳞状上皮的化生能增强粘膜的抵抗力,使粘膜在不利的情况下仍能生存。但支气管柱状上皮发生鳞状上皮化生时,丧失了纤毛,削弱了呼吸道的防御功能使易受感染。有时化生的细胞可以发生恶性肿瘤。如化生的鳞状上皮,有时未能分化成熟,产生不典型增生,可进而发生恶变,发生浸润成为鳞状细胞癌。胃粘膜的肠上皮化生与胃癌的发生可能有密切关系。

宫颈鳞状化生
癌变(Carcinogenesis)
从细胞水平上癌的发生是极偶然的事件,从遗传上癌都是由一个细胞发展而来,由一个失去了增殖控制的细胞发展而来。癌细胞除了生长失控外,还会局部侵入周遭正常组织甚至经由体内循环系统或淋巴系统转移到身体其他部分,不受限制,可以长期增殖下去。癌细胞的基因组、形态结构和细胞表面均发生了变化,细胞膜上的糖蛋白等物质减少,细胞彼此之间的粘着性减小,癌细胞容易在有机体内分散和转移。来源于间叶组织的恶性肿瘤称为“肉瘤”,多发生于皮肤、皮下、骨膜及长骨两端,多见于年轻人。异形细胞占据全层但没有突破基底膜的称为原位癌或上皮内癌,多见于老年人。白血病亦称作血癌,是造血干细胞的恶性增生性病变,其克隆中的白血病细胞失去进一步分化成熟的能力而停滞在细胞发育的不同阶段。
脂肪肉瘤
侵润(infiltration)
人体组织内侵入了异常细胞或出现了正常情况下不应出现的机体细胞,以及某些病变组织向周围扩展的现象。在细胞内或间质中出现异常的物质或原有的某些物质的堆积过多也称为浸润。浸润也可见于治疗中,除了为了治疗目的使用药物浸润以及炎症灶中各种炎细胞浸润外,其他任何浸润对机体都是有害的,其损害的大小要看浸润的物质的性质、多少以及受累器官功能的影响而定。恶性肿瘤细胞可以浸润周围的正常组织,在质和量方面异常地分布于组织间隙的现象,这称为肿瘤细胞浸润,是肿瘤细胞粘连、酶降解、移动、基质内增殖等一系列过程的表现,往往是恶性肿瘤的特征。

欧根·埃利希癌侵润
转移(Metastasis)
恶性肿瘤细胞从原发部位,经淋巴道, 血管或体腔等途径,到达其他部位继续生长,称肿瘤转移,良性肿瘤无转移,恶性肿瘤容易发生转移。转移方式包括直接蔓延、经淋巴转移、经血行转移、种植性转移四种方式。当含有癌细胞的淋巴液进入血液后,或癌细胞直接侵入小血管,就可能发生血行转移。进入血液中的癌细胞以单个细胞或由纤维素连成一团的形式在血流中移动。一般进入血循环中的癌细胞不能存活,但当它们在运行过程中得到停留的机会,则会侵出管壁并进入血管周围的间质,生长成转移灶,挤压、局部手术操作可能增加转移的机会。机体不同的组织对转移有不同的亲和性,肝、肺、骨髓、脑及肾上腺为常见的转移部位,而脾、肌肉等则很少出现转移。一般血行转移多在病情的后期发生,但肺癌、乳腺癌、肾癌、脑癌、前列腺癌及甲状腺癌等早期即可有血行转移。常见的肿瘤转移部位是肺、肝、骨、脑等。转移癌并不一定是癌症的晚期,某些癌症的早期也可发生转移。显然,恶性肿瘤转移将增加对机体的损害作用,而且影响转归。
淋巴结癌转移
文:老狼


